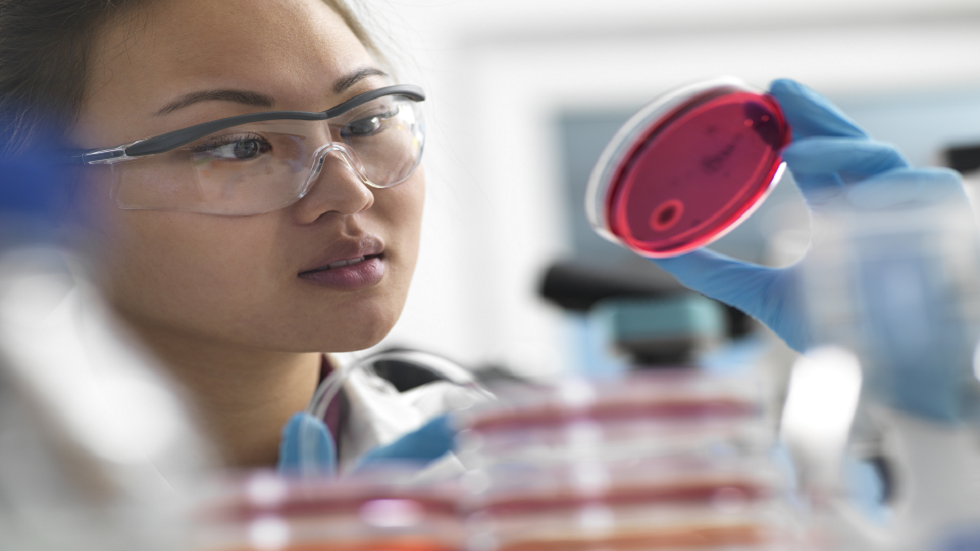
الصين.. دراسة وراثية شاملة تعد باكتشافات طبية هامة!

Stories
-
![إيران تقصف إسرائيل ردا على استهداف الضاحية]()
إيران تقصف إسرائيل ردا على استهداف الضاحية
RT STORIES
مستشار خامنئي يوجه رسالة تحذيرية لواشنطن ويهدد بإغلاق مضيق باب المندب
![مستشار خامنئي يوجه رسالة تحذيرية لواشنطن ويهدد بإغلاق مضيق باب المندب]() #اسأل_أكثر #Question_More
#اسأل_أكثر #Question_MoreRT STORIES
إسرائيل تغلق معابر غزة عقب الهجمات الصاروخية الإيرانية حتى إشعار آخر
![إسرائيل تغلق معابر غزة عقب الهجمات الصاروخية الإيرانية حتى إشعار آخر]() #اسأل_أكثر #Question_More
#اسأل_أكثر #Question_MoreRT STORIES
"يديعوت أحرونوت": الجيش الإسرائيلي رصد حوالي أربع عمليات إطلاق صواريخ من إيران نحو إسرائيل
!["يديعوت أحرونوت": الجيش الإسرائيلي رصد حوالي أربع عمليات إطلاق صواريخ من إيران نحو إسرائيل]() #اسأل_أكثر #Question_More
#اسأل_أكثر #Question_MoreRT STORIES
الجيش الإسرائيلي: وابل جديد من الصواريخ من إيران باتجاه إسرائيل
![الجيش الإسرائيلي: وابل جديد من الصواريخ من إيران باتجاه إسرائيل]() #اسأل_أكثر #Question_More
#اسأل_أكثر #Question_MoreRT STORIES
بيان من مقر خاتم الأنبياء عن الهجوم الإيراني على إسرائيل ردا على قصف الضاحية
![بيان من مقر خاتم الأنبياء عن الهجوم الإيراني على إسرائيل ردا على قصف الضاحية]() #اسأل_أكثر #Question_More
#اسأل_أكثر #Question_MoreRT STORIES
"حنظلة الإيرانية": ننفذ الآن هجوما إلكترونيا ضد إسرائيل
!["حنظلة الإيرانية": ننفذ الآن هجوما إلكترونيا ضد إسرائيل]() #اسأل_أكثر #Question_More
#اسأل_أكثر #Question_MoreRT STORIES
الحرس الثوري الإيراني يكشف تفاصيل الهجوم الإيراني على إسرائيل
![الحرس الثوري الإيراني يكشف تفاصيل الهجوم الإيراني على إسرائيل]() #اسأل_أكثر #Question_More
#اسأل_أكثر #Question_MoreRT STORIES
موجات صاروخية متتالية تضرب إسرائيل (فيديوهات)
![موجات صاروخية متتالية تضرب إسرائيل (فيديوهات)]() #اسأل_أكثر #Question_More
#اسأل_أكثر #Question_MoreRT STORIES
ترامب في تصريح مفاجئ: أقول لإيران لقد أطلقتم صواريخكم على إسرائيل وهذا يكفي
![ترامب في تصريح مفاجئ: أقول لإيران لقد أطلقتم صواريخكم على إسرائيل وهذا يكفي]() #اسأل_أكثر #Question_More
#اسأل_أكثر #Question_MoreRT STORIES
ترامب لفوكس نيوز: لست سعيدا بوقوع الهجوم الإسرائيلي على بيروت
![ترامب لفوكس نيوز: لست سعيدا بوقوع الهجوم الإسرائيلي على بيروت]() #اسأل_أكثر #Question_More
#اسأل_أكثر #Question_MoreRT STORIES
ترامب لأكسيوس: سأتصل بنتنياهو الآن وأطلب منه عدم الرد على إيران
![ترامب لأكسيوس: سأتصل بنتنياهو الآن وأطلب منه عدم الرد على إيران]() #اسأل_أكثر #Question_More
#اسأل_أكثر #Question_MoreRT STORIES
زامير ينتظر "الضوء الأخضر" للرد ومسؤول إسرائيلي يقول: إسرائيل تستعد لهجوم قوي على إيران
![زامير ينتظر "الضوء الأخضر" للرد ومسؤول إسرائيلي يقول: إسرائيل تستعد لهجوم قوي على إيران]() #اسأل_أكثر #Question_More
#اسأل_أكثر #Question_MoreRT STORIES
بعد الهجوم الإيراني نتنياهو أمام أخطر اختبار: رد قاس أو ثمن سياسي باهظ
![بعد الهجوم الإيراني نتنياهو أمام أخطر اختبار: رد قاس أو ثمن سياسي باهظ]() #اسأل_أكثر #Question_More
#اسأل_أكثر #Question_MoreRT STORIES
مشاورات مصرية إيرانية بعد الهجوم على إسرائيل
![مشاورات مصرية إيرانية بعد الهجوم على إسرائيل]() #اسأل_أكثر #Question_More
#اسأل_أكثر #Question_MoreRT STORIES
عراقجي يبحث مع نظرائه في فرنسا وبريطانيا وتركيا وقائد الجيش الباكستاني قصف إيران لإسرائيل
![عراقجي يبحث مع نظرائه في فرنسا وبريطانيا وتركيا وقائد الجيش الباكستاني قصف إيران لإسرائيل]() #اسأل_أكثر #Question_More
#اسأل_أكثر #Question_MoreRT STORIES
"خاتم الأنبياء" يتوعد إسرائيل: ردنا سيكون مدمرا في حال قصفتم إيران.. سنوجه ضربة ساحقة لتل أبيب
!["خاتم الأنبياء" يتوعد إسرائيل: ردنا سيكون مدمرا في حال قصفتم إيران.. سنوجه ضربة ساحقة لتل أبيب]() #اسأل_أكثر #Question_More
#اسأل_أكثر #Question_MoreRT STORIES
النفط يقفز بأكثر من 3% مع تصاعد التوتر بين إسرائيل وإيران
![النفط يقفز بأكثر من 3% مع تصاعد التوتر بين إسرائيل وإيران]() #اسأل_أكثر #Question_More
#اسأل_أكثر #Question_MoreRT STORIES
عقب طلب ترامب بعدم الرد.. نتنياهو يبحث مع قادة الجيش الهجوم الصاروخي الإيراني على إسرائيل
![عقب طلب ترامب بعدم الرد.. نتنياهو يبحث مع قادة الجيش الهجوم الصاروخي الإيراني على إسرائيل]() #اسأل_أكثر #Question_More
#اسأل_أكثر #Question_More![إيران تقصف إسرائيل ردا على استهداف الضاحية]() إيران تقصف إسرائيل ردا على استهداف الضاحية
إيران تقصف إسرائيل ردا على استهداف الضاحية
-
![كأس العالم لكرة القدم]()
كأس العالم لكرة القدم
RT STORIES
وسط الحرب مع أمريكا.. إيران تبدأ الاستعدادات لكأس العالم من المكسيك (فيديو)
![وسط الحرب مع أمريكا.. إيران تبدأ الاستعدادات لكأس العالم من المكسيك (فيديو)]() #اسأل_أكثر #Question_More
#اسأل_أكثر #Question_MoreRT STORIES
برشلونة يعطي الضوء الأخضر للمنتخب الإسباني بشأن موعد عودة لامين جمال
![برشلونة يعطي الضوء الأخضر للمنتخب الإسباني بشأن موعد عودة لامين جمال]() #اسأل_أكثر #Question_More
#اسأل_أكثر #Question_More![كأس العالم لكرة القدم]() كأس العالم لكرة القدم
كأس العالم لكرة القدم
-
![هدنة وحصار المضيق]()
هدنة وحصار المضيق
RT STORIES
قاليباف: القواعد والمصالح الأمريكية والإسرائيلية في المنطقة أهداف مشروعة لنا وقواتنا يدها طليقة للرد
![قاليباف: القواعد والمصالح الأمريكية والإسرائيلية في المنطقة أهداف مشروعة لنا وقواتنا يدها طليقة للرد]() #اسأل_أكثر #Question_More
#اسأل_أكثر #Question_MoreRT STORIES
هيغسيث يؤكد أن وقف إطلاق النار بين أمريكا وإيران صامد رغم الاشتباكات
![هيغسيث يؤكد أن وقف إطلاق النار بين أمريكا وإيران صامد رغم الاشتباكات]() #اسأل_أكثر #Question_More
#اسأل_أكثر #Question_MoreRT STORIES
"عامل مجتبى والنافذة الضيقة": تقرير عبري عن كسر إيران للفتوى النووية وخيارات ترامب "غير السحرية"
!["عامل مجتبى والنافذة الضيقة": تقرير عبري عن كسر إيران للفتوى النووية وخيارات ترامب "غير السحرية"]() #اسأل_أكثر #Question_More
#اسأل_أكثر #Question_MoreRT STORIES
سائح يوثق طوابير السفن والناقلات العالقة في مضيق هرمز (فيديو)
![سائح يوثق طوابير السفن والناقلات العالقة في مضيق هرمز (فيديو)]() #اسأل_أكثر #Question_More
#اسأل_أكثر #Question_MoreRT STORIES
الجيش الأمريكي يعلن إسقاط مسيرتين إيرانيتين في مضيق هرمز
![الجيش الأمريكي يعلن إسقاط مسيرتين إيرانيتين في مضيق هرمز]() #اسأل_أكثر #Question_More
#اسأل_أكثر #Question_MoreRT STORIES
مسؤول استخباراتي أمريكي بارز يؤكد أن استئناف الضربات على إيران حتمي ويذكر السبب
![مسؤول استخباراتي أمريكي بارز يؤكد أن استئناف الضربات على إيران حتمي ويذكر السبب]() #اسأل_أكثر #Question_More
#اسأل_أكثر #Question_MoreRT STORIES
"فارس" تنشر صورا تظهر "الدمار" إثر الهجوم الإيراني الأخير على قاعدة عسكرية في الكويت (صورة)
!["فارس" تنشر صورا تظهر "الدمار" إثر الهجوم الإيراني الأخير على قاعدة عسكرية في الكويت (صورة)]() #اسأل_أكثر #Question_More
#اسأل_أكثر #Question_MoreRT STORIES
إعلام: واشنطن تنوي استخدام الأصول الإيرانية المجمدة لدعم حلفائها الخليجيين
![إعلام: واشنطن تنوي استخدام الأصول الإيرانية المجمدة لدعم حلفائها الخليجيين]() #اسأل_أكثر #Question_More
#اسأل_أكثر #Question_MoreRT STORIES
وزير الداخلية الباكستاني من طهران: أنا هنا لأُبلغ رسالة خاصة إلى المرشد الأعلى
![وزير الداخلية الباكستاني من طهران: أنا هنا لأُبلغ رسالة خاصة إلى المرشد الأعلى]() #اسأل_أكثر #Question_More
#اسأل_أكثر #Question_MoreRT STORIES
المنامة تضع أمام طهران خيارين لا ثالث لهما وتذكرها بخط أحمر بعد هجماتها الجديدة على البحرين والكويت
![المنامة تضع أمام طهران خيارين لا ثالث لهما وتذكرها بخط أحمر بعد هجماتها الجديدة على البحرين والكويت]() #اسأل_أكثر #Question_More
#اسأل_أكثر #Question_MoreRT STORIES
مجلة عسكرية: خروج مركز العمليات الجوية الأمريكية في قاعدة العديد بقطر عن الخدمة
![مجلة عسكرية: خروج مركز العمليات الجوية الأمريكية في قاعدة العديد بقطر عن الخدمة]() #اسأل_أكثر #Question_More
#اسأل_أكثر #Question_MoreRT STORIES
"ترامب سيرحل".. سياسي إيراني يقترح حلا لأزمة البرنامج النووي
!["ترامب سيرحل".. سياسي إيراني يقترح حلا لأزمة البرنامج النووي]() #اسأل_أكثر #Question_More
#اسأل_أكثر #Question_MoreRT STORIES
الحرس الثوري الإيراني: قصفنا قاعدة علي السالم بالكويت والأسطول الخامس بالبحرين
![الحرس الثوري الإيراني: قصفنا قاعدة علي السالم بالكويت والأسطول الخامس بالبحرين]() #اسأل_أكثر #Question_More
#اسأل_أكثر #Question_MoreRT STORIES
إنذارات بهجمات صاروخية ومسيرات معادية في الكويت والبحرين (فيديوهات)
![إنذارات بهجمات صاروخية ومسيرات معادية في الكويت والبحرين (فيديوهات)]() #اسأل_أكثر #Question_More
#اسأل_أكثر #Question_MoreRT STORIES
مبعوثا ترامب إلى إيران يجريان محادثات سرية مع خبراء نوويين في تينيسي
![مبعوثا ترامب إلى إيران يجريان محادثات سرية مع خبراء نوويين في تينيسي]() #اسأل_أكثر #Question_More
#اسأل_أكثر #Question_More![هدنة وحصار المضيق]() هدنة وحصار المضيق
هدنة وحصار المضيق
-
![فيديوهات]()
فيديوهات
RT STORIES
إيرانيون يشاهدون صواريخ منطلقة صوب إسرائيل أثناء تجمع حاشد غربي البلاد
![إيرانيون يشاهدون صواريخ منطلقة صوب إسرائيل أثناء تجمع حاشد غربي البلاد]() #اسأل_أكثر #Question_More
#اسأل_أكثر #Question_MoreRT STORIES
مراسم عسكرية تكريما لجنرال لبناني قتل في غارة جوية إسرائيلية
![مراسم عسكرية تكريما لجنرال لبناني قتل في غارة جوية إسرائيلية]() #اسأل_أكثر #Question_More
#اسأل_أكثر #Question_MoreRT STORIES
المنتخب الإيراني يصل إلى المكسيك استعدادا لكأس العالم
![المنتخب الإيراني يصل إلى المكسيك استعدادا لكأس العالم]() #اسأل_أكثر #Question_More
#اسأل_أكثر #Question_MoreRT STORIES
قنابل حائمة موجهة روسية تسوي مراكز التحكم بالمسيرات ومواقع انتشار لقوات أوكرانية بالأرض
![قنابل حائمة موجهة روسية تسوي مراكز التحكم بالمسيرات ومواقع انتشار لقوات أوكرانية بالأرض]() #اسأل_أكثر #Question_More
#اسأل_أكثر #Question_MoreRT STORIES
البرازيل.. لحظة انهيار جسر تم بناؤه قبل عامين
![البرازيل.. لحظة انهيار جسر تم بناؤه قبل عامين]() #اسأل_أكثر #Question_More
#اسأل_أكثر #Question_MoreRT STORIES
رياح عاتية تقتلع خيمة ضخمة كبيرة في ملعب جامعة ويست فرجينيا الأمريكية
![رياح عاتية تقتلع خيمة ضخمة كبيرة في ملعب جامعة ويست فرجينيا الأمريكية]() #اسأل_أكثر #Question_More
#اسأل_أكثر #Question_MoreRT STORIES
كيم جونغ أون ينضم إلى آلاف الأطفال في احتفال بيونغ يانغ الكبير
![كيم جونغ أون ينضم إلى آلاف الأطفال في احتفال بيونغ يانغ الكبير]() #اسأل_أكثر #Question_More
#اسأل_أكثر #Question_MoreRT STORIES
مياه الفيضانات تبتلع منازل في مقاطعة قويتشو الصينية
![مياه الفيضانات تبتلع منازل في مقاطعة قويتشو الصينية]() #اسأل_أكثر #Question_More
#اسأل_أكثر #Question_MoreRT STORIES
امرأة تنجو بأعجوبة أثناء عاصفة قوية في الصين
![امرأة تنجو بأعجوبة أثناء عاصفة قوية في الصين]() #اسأل_أكثر #Question_More
#اسأل_أكثر #Question_MoreRT STORIES
صورة ساخرة لنتنياهو تظهر على صواريخ في لقطات جديدة للحرس الثوري الإيراني
![صورة ساخرة لنتنياهو تظهر على صواريخ في لقطات جديدة للحرس الثوري الإيراني]() #اسأل_أكثر #Question_More
#اسأل_أكثر #Question_More![فيديوهات]() فيديوهات
فيديوهات
-
![اتفاق وقف إطلاق النار بين إسرائيل ولبنان]()
اتفاق وقف إطلاق النار بين إسرائيل ولبنان
RT STORIES
الجيش الإسرائيلي يصدر بيانا عن استهداف الضاحية الجنوبية لبيروت (فيديو)
![الجيش الإسرائيلي يصدر بيانا عن استهداف الضاحية الجنوبية لبيروت (فيديو)]() #اسأل_أكثر #Question_More
#اسأل_أكثر #Question_MoreRT STORIES
بأوامر من نتنياهو وكاتس.. دمار كبير جراء استهداف الضاحية الجنوبية لبيروت (فيديوهات)
![بأوامر من نتنياهو وكاتس.. دمار كبير جراء استهداف الضاحية الجنوبية لبيروت (فيديوهات)]() #اسأل_أكثر #Question_More
#اسأل_أكثر #Question_MoreRT STORIES
الجيش الإسرائيلي يكشف عن موقع تحت أرضي لحزب الله في منطقة قلعة الشقيف
![الجيش الإسرائيلي يكشف عن موقع تحت أرضي لحزب الله في منطقة قلعة الشقيف]() #اسأل_أكثر #Question_More
#اسأل_أكثر #Question_MoreRT STORIES
إصابة 4 جنود إسرائيليين استهدفتهم مسيرة في جنوب لبنان
![إصابة 4 جنود إسرائيليين استهدفتهم مسيرة في جنوب لبنان]() #اسأل_أكثر #Question_More
#اسأل_أكثر #Question_MoreRT STORIES
مصر توجه تحذيرا بعد اعتداء إسرائيل على الجيش اللبناني
![مصر توجه تحذيرا بعد اعتداء إسرائيل على الجيش اللبناني]() #اسأل_أكثر #Question_More
#اسأل_أكثر #Question_MoreRT STORIES
فيديو يظهر انقضاض مسيّرات "حزب الله" المفخخة على آليات عسكرية إسرائيلية في جنوب لبنان (فيديو)
![فيديو يظهر انقضاض مسيّرات "حزب الله" المفخخة على آليات عسكرية إسرائيلية في جنوب لبنان (فيديو)]() #اسأل_أكثر #Question_More
#اسأل_أكثر #Question_MoreRT STORIES
مقتل ضابط وجندي إسرائيليين في جنوب لبنان
![مقتل ضابط وجندي إسرائيليين في جنوب لبنان]() #اسأل_أكثر #Question_More
#اسأل_أكثر #Question_MoreRT STORIES
"هامر عسكرية احترقت بمن فيها".. "حزب الله" ينشر ملخص عملياته ضد الجيش الإسرائيلي يوم السبت
!["هامر عسكرية احترقت بمن فيها".. "حزب الله" ينشر ملخص عملياته ضد الجيش الإسرائيلي يوم السبت]() #اسأل_أكثر #Question_More
#اسأل_أكثر #Question_MoreRT STORIES
قائد الجيش اللبناني رودولف هيكل يتوجه إلى باكستان
![قائد الجيش اللبناني رودولف هيكل يتوجه إلى باكستان]() #اسأل_أكثر #Question_More
#اسأل_أكثر #Question_MoreRT STORIES
"حزب الله": الاتفاق مع إسرائيل عار واستسلام والبعض في لبنان يعاني نقص مناعة وطنية
!["حزب الله": الاتفاق مع إسرائيل عار واستسلام والبعض في لبنان يعاني نقص مناعة وطنية]() #اسأل_أكثر #Question_More
#اسأل_أكثر #Question_MoreRT STORIES
مقتل ضابط وسائقه استهدفتهما مسيرة إسرائيلية في جنوب لبنان
![مقتل ضابط وسائقه استهدفتهما مسيرة إسرائيلية في جنوب لبنان]() #اسأل_أكثر #Question_More
#اسأل_أكثر #Question_MoreRT STORIES
صحيفة إسرائيلية تكشف تفاصيل جديدة عن اغتيال نصر الله: كواليس "دقيقة بدقيقة" في بيروت
![صحيفة إسرائيلية تكشف تفاصيل جديدة عن اغتيال نصر الله: كواليس "دقيقة بدقيقة" في بيروت]() #اسأل_أكثر #Question_More
#اسأل_أكثر #Question_MoreRT STORIES
جنبلاط يحذر من تكرار تجربة أوسلو ومصير فلسطين في المفاوضات مع إسرائيل
![جنبلاط يحذر من تكرار تجربة أوسلو ومصير فلسطين في المفاوضات مع إسرائيل]() #اسأل_أكثر #Question_More
#اسأل_أكثر #Question_More![اتفاق وقف إطلاق النار بين إسرائيل ولبنان]() اتفاق وقف إطلاق النار بين إسرائيل ولبنان
اتفاق وقف إطلاق النار بين إسرائيل ولبنان
-
![العملية العسكرية الروسية في أوكرانيا]()
العملية العسكرية الروسية في أوكرانيا
RT STORIES
أوكرانيا.. أربع حالات وفاة داخل مكاتب التعبئة
![أوكرانيا.. أربع حالات وفاة داخل مكاتب التعبئة]() #اسأل_أكثر #Question_More
#اسأل_أكثر #Question_MoreRT STORIES
جندي روسي يسقط 6 مسيّرات هاجمته في آن واحد
![جندي روسي يسقط 6 مسيّرات هاجمته في آن واحد]() #اسأل_أكثر #Question_More
#اسأل_أكثر #Question_MoreRT STORIES
تعرّض بلدة في مقاطعة خيرسون لهجوم بـ13 مسيرة أوكرانية
![تعرّض بلدة في مقاطعة خيرسون لهجوم بـ13 مسيرة أوكرانية]() #اسأل_أكثر #Question_More
#اسأل_أكثر #Question_MoreRT STORIES
إيرول ماسك: لم يكن أمام روسيا سوى الدفاع عن شعب دونباس
![إيرول ماسك: لم يكن أمام روسيا سوى الدفاع عن شعب دونباس]() #اسأل_أكثر #Question_More
#اسأل_أكثر #Question_MoreRT STORIES
الكرملين: واشنطن تحاول الانسحاب من مفاوضات أوكرانيا بعد إدراكها حتمية انتصار روسيا
![الكرملين: واشنطن تحاول الانسحاب من مفاوضات أوكرانيا بعد إدراكها حتمية انتصار روسيا]() #اسأل_أكثر #Question_More
#اسأل_أكثر #Question_MoreRT STORIES
موسكو تندد بصمت الأمم المتحدة بشأن مجزرة ستاروبيلسك: ادعاءات عدم التحقق لا أساس لها
![موسكو تندد بصمت الأمم المتحدة بشأن مجزرة ستاروبيلسك: ادعاءات عدم التحقق لا أساس لها]() #اسأل_أكثر #Question_More
#اسأل_أكثر #Question_MoreRT STORIES
ضابط أمريكي متقاعد: رسالة زيلينسكي إلى بوتين كان هدفها استفزاز روسيا وليس التوصل إلى تسوية
![ضابط أمريكي متقاعد: رسالة زيلينسكي إلى بوتين كان هدفها استفزاز روسيا وليس التوصل إلى تسوية]() #اسأل_أكثر #Question_More
#اسأل_أكثر #Question_MoreRT STORIES
الدفاع الجوي يسقط مسيرة كانت متجهة نحو موسكو
![الدفاع الجوي يسقط مسيرة كانت متجهة نحو موسكو]() #اسأل_أكثر #Question_More
#اسأل_أكثر #Question_MoreRT STORIES
الأمن الأوكراني ربما صفى ضابطا في القوات الخاصة بسبب انتقاده لسيرسكي
![الأمن الأوكراني ربما صفى ضابطا في القوات الخاصة بسبب انتقاده لسيرسكي]() #اسأل_أكثر #Question_More
#اسأل_أكثر #Question_MoreRT STORIES
سلوتسكي: لا مجال للتسويات بعد جرائم أوكرانيا والنصر الروسي هو الحل الوحيد
![سلوتسكي: لا مجال للتسويات بعد جرائم أوكرانيا والنصر الروسي هو الحل الوحيد]() #اسأل_أكثر #Question_More
#اسأل_أكثر #Question_MoreRT STORIES
بيسكوف يدعو إلى "عدم التسرع في الاستنتاجات" بشأن رسالة زيلينسكي إلى بوتين
![بيسكوف يدعو إلى "عدم التسرع في الاستنتاجات" بشأن رسالة زيلينسكي إلى بوتين]() #اسأل_أكثر #Question_More
#اسأل_أكثر #Question_MoreRT STORIES
نائبة في البرلمان الأوروبي عن رومانيا: الاتحاد الأوروبي والناتو يجراننا إلى حرب لا تعنينا
![نائبة في البرلمان الأوروبي عن رومانيا: الاتحاد الأوروبي والناتو يجراننا إلى حرب لا تعنينا]() #اسأل_أكثر #Question_More
#اسأل_أكثر #Question_MoreRT STORIES
الدفاع الروسية: تدمير واعتراض 339 مسيرة أوكرانية خلال 13 ساعة
![الدفاع الروسية: تدمير واعتراض 339 مسيرة أوكرانية خلال 13 ساعة]() #اسأل_أكثر #Question_More
#اسأل_أكثر #Question_MoreRT STORIES
إعلام إيطالي: ميلوني متشككة تجاه أفكار باريس وبرلين بشأن أوكرانيا
![إعلام إيطالي: ميلوني متشككة تجاه أفكار باريس وبرلين بشأن أوكرانيا]() #اسأل_أكثر #Question_More
#اسأل_أكثر #Question_MoreRT STORIES
فتاة ترش ضابطا بالغاز لمنعه من اختطاف حبيبها للتجنيد الإجباري في كييف
![فتاة ترش ضابطا بالغاز لمنعه من اختطاف حبيبها للتجنيد الإجباري في كييف]() #اسأل_أكثر #Question_More
#اسأل_أكثر #Question_MoreRT STORIES
القوات الروسية تطوق تجمعا لقوات كييف شمال سفياتوغورسك في دونيتسك
![القوات الروسية تطوق تجمعا لقوات كييف شمال سفياتوغورسك في دونيتسك]() #اسأل_أكثر #Question_More
#اسأل_أكثر #Question_MoreRT STORIES
إسقاط 25 مسيرة في مقاطعة لينينغراد الروسية
![إسقاط 25 مسيرة في مقاطعة لينينغراد الروسية]() #اسأل_أكثر #Question_More
#اسأل_أكثر #Question_MoreRT STORIES
بوتين: كييف تريد وقف تقدم قواتنا ونحن مستعدون لاتفاقيات طويلة الأمد
![بوتين: كييف تريد وقف تقدم قواتنا ونحن مستعدون لاتفاقيات طويلة الأمد]() #اسأل_أكثر #Question_More
#اسأل_أكثر #Question_MoreRT STORIES
أوشاكوف: بوتين أجري محادثة ودية مع المستشار الألماني الأسبق شرودر في الكرملين
![أوشاكوف: بوتين أجري محادثة ودية مع المستشار الألماني الأسبق شرودر في الكرملين]() #اسأل_أكثر #Question_More
#اسأل_أكثر #Question_MoreRT STORIES
إعلام: زيلينسكي يريد مناقشة مفاوضات محتملة مع روسيا مع شركائه
![إعلام: زيلينسكي يريد مناقشة مفاوضات محتملة مع روسيا مع شركائه]() #اسأل_أكثر #Question_More
#اسأل_أكثر #Question_More![العملية العسكرية الروسية في أوكرانيا]() العملية العسكرية الروسية في أوكرانيا
العملية العسكرية الروسية في أوكرانيا
-
![فنان أمريكي يقاضي "فيفا" ويطالب بـ25 مليون دولار]()
فنان أمريكي يقاضي "فيفا" ويطالب بـ25 مليون دولار
RT STORIES
فنان أمريكي يقاضي "فيفا" ويطالب بـ25 مليون دولار
![فنان أمريكي يقاضي "فيفا" ويطالب بـ25 مليون دولار]() #اسأل_أكثر #Question_More
#اسأل_أكثر #Question_More -
![نائب أوروبي يطالب بحرمان دول البلطيق من حماية "الناتو" جراء استفزازاتها ضد روسيا]()
نائب أوروبي يطالب بحرمان دول البلطيق من حماية "الناتو" جراء استفزازاتها ضد روسيا
RT STORIES
نائب أوروبي يطالب بحرمان دول البلطيق من حماية "الناتو" جراء استفزازاتها ضد روسيا
![نائب أوروبي يطالب بحرمان دول البلطيق من حماية "الناتو" جراء استفزازاتها ضد روسيا]() #اسأل_أكثر #Question_More
#اسأل_أكثر #Question_More
الصين.. دراسة وراثية شاملة تعد باكتشافات طبية هامة!
أجرى فريق من الباحثين في مركز قوانغتشو الطبي للنساء والأطفال، دراسة وراثية واسعة النطاق شملت تحليل بيانات التسلسل الجيني لآلاف المشاركين الصينيين.
ونشر نيكولاس جون تيمبسون، من جامعة بريستول، مقالا بعنوان "الأخبار والآراء" في مجلة Nature، يوضح الأفكار الكامنة وراء تحديد الاختلافات الجينية في مجموعات سكانية معينة ولمحة عامة عن العمل الذي قام به الفريق الصيني.
ومع استمرار دراسة التسلسل الجيني واستخدام البيانات الجينية، يبحث العلماء عن طرق جديدة لعلاج المرضى بناء على ملفهم الجيني الفريد.

اختبار دم جديد يحدد سبب إصابة الدماغ عند حديثي الولادة
وحلل الفريق الصيني البيانات الجينية على مدى العقد الماضي، حيث جُمعت البيانات الوراثية من الأشخاص المولودين في قوانغتشو ومن الوالدين. وحتى الآن، تم تحليل البيانات من نحو 4000 شخص ومن 58000 طفل حديث الولادة.
وبالإضافة إلى البيانات الوراثية، جمع الباحثون أيضا البيانات الوبائية للأفراد، مثل الطول والوزن، ومعلومات أخرى بما في ذلك التاريخ الطبي.
واكتشف فريق البحث متغيرات جينية يمكن أن تؤثر على صحة الشخص ورفاهيته مع تقدمه في السن. وارتبط أحد المتغيرات بزيادة الوزن أثناء الحمل، وارتبط متغير آخر بتطور ركود صفراوي والإفراط في إنتاج الصفراء لدى النساء الحوامل، ما يؤدي إلى جفاف الجلد وحكة للأم واليرقان أو في بعض الأحيان وفاة الطفل.
ويشير الباحثون إلى أن هذا المتغير يبدو أكثر انتشارا بين الأمهات في شرق آسيا. ووجدوا أيضا متغيرات يبدو أنها تفسر مستويات الكوليسترول غير الطبيعية لدى الأم أو الطفل أو كليهما.
ووجد فريق البحث أيضا متغيرات يبدو أنها تلعب دورا في الخصائص الجسدية، على سبيل المثال، وُجد أن الأمهات طويلات القامة اللاتي يعانين من ارتفاع نسبة السكر في الدم، يلدن أطفالا أكثر وزنا إذا صمن أثناء الحمل، في حين أن الأمهات اللاتي يعانين من ارتفاع ضغط الدم يميلن إلى إنجاب أطفال أقصر قامة.
المصدر: ميديكال إكسبريس





























































































































































































التعليقات